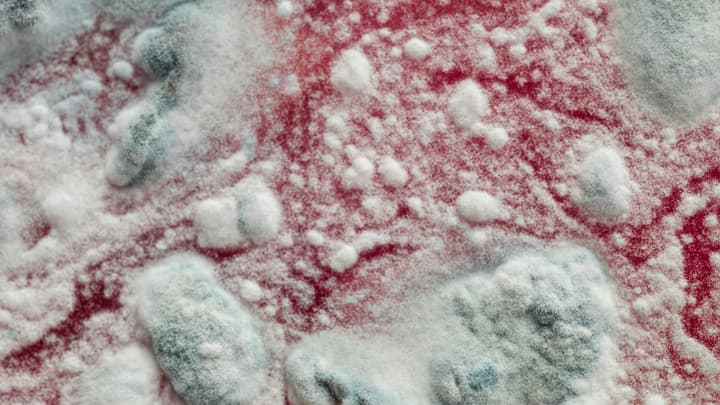
Alergia na grzyby pleśniowe

Alergia na jad owadów to nieprawidłowa reakcja układu immunologicznego na związki obecne w jadzie owadów. Objawia się zmianami na skórze i kłopotami z oddychaniem. Stanowi zagrożenie dla życia.
Czym jest alergia na jad owadów?
Dla większości osób użądlenia przez owady są nieprzyjemne, ale niegroźne. Czasem jednak wywołują alergię. Najgorszej jest w przypadku os, pszczół, trzmieli czy szerszeni.
Za alergię na jad owadów odpowiada niewłaściwa reakcja układu immunologicznego, który broni organizm przed szkodliwymi drobnoustrojami. Czasem jednak z nieznanego powodu za takie substancje uznaje alergeny. Zaczyna wtedy z nimi walczyć.
Do organizmu człowieka jad dostaje się w czasie ukąszenia. Owady atakują, bo czują się zagrożone. Osa użądlić może wiele razy, ale dla pszczoły użądlenie oznacza śmierć. Jad owadów zawiera wiele związków chemicznych, z których niektóre odpowiadają za reakcje alergiczne. W przypadku os jest to antygen 5, hialuronidaza i fosfolipaza A. U pszczół alergie powodują melityna, fosfolipaza kwaśna i hialuronidaza.
Alergia na jad owadów - przyczyny i objawy
Okazuje się, że rozwojowi alergii na jad owadów sprzyjają:
- kilkukrotne użądlenie przez owady w przeszłości,
- występowanie innych rodzajów alergii,
- czynniki środowiskowe np. duża liczba pszczół w okolicy.
Objawy alergiczne mają różne nasilenie. Zazwyczaj jest to pieczenie, świąd, zaczerwienienie, pokrzywka, obrzęk, ból brzucha czy osłabienie. Czasem dochodzi też do ciężkich reakcji alergicznych, które są groźne dla zdrowia. Wtedy trzeba niezwłocznie wezwać pogotowie. Takie objawy rozwijają się do 30 minut od momentu użądlenia. Są to:
- szybki spadek ciśnienia krwi,
- zaburzenia połykania,
- zawroty głowy,
- zaburzenia mowy,
- nudności, wymioty, biegunki,
- trudności z oddychaniem,
- ból w klatce piersiowej,
- utrata świadomości.
Alergia na jad owadów - diagnostyka
Objawy alergii są na ogół dość charakterystyczne. Osoby, które je zaobserwowały, powinny skontaktować się z lekarzem pierwszego kontaktu. On ocenia ich nasilenie i w razie potrzeby rozpocznie odpowiednie leczenie. Czasem konieczna jest pomoc alergologa lub immunologa.
Powiązanie objawów alergii z użądleniem nie jest trudne. Gorzej jest z wytypowaniem, który owad za nią odpowiada. Do tego potrzebne są odpowiednie testy:
- Testy skórne z użyciem rozcieńczonych wyciągów z najczęściej uczulających jadów owadów.
- Badanie krwi np. test RAST, który bada poziom immunoglobuliny skierowanej przeciwko danego alergenowi.
- Prowokacyjne próby użądleniowe, co odbywa się w warunkach szpitalnych.
Alergia na jad owadów - leczenie
Leczenie alergii na jad owadów składa się z:
- zapobiegania sytuacji, w których może dojść do użądlenie, co bywa trudne,
- leczenie objawowego z użyciem różnych leków łagodzących zmiany skórne i nie tylko: to głównie preparaty antyhistaminowe, rzadziej glikokortykosteroidy czy adrenalina.
W przypadku ciężkiej reakcji alergicznej trzeba szybko usunąć żądło, podać adrenalinę i wezwać pogotowie ratunkowe. Osoby, które wiedzą, że cierpią na ciężką postać alergii na jad owadów, muszą mieć zawsze przy sobie glikokortykosteroidy w tabletkach, leki przeciwhistaminowe o szybkim działaniu i adrenalinę do samodzielnego podania.
Czasem przeprowadza się też leczenie odczulające. Szczepionki są dobierane indywidualnie i mają formę zastrzyków podskórnych. Nie sprawdzają się jednak u wszystkich osób. Ostateczna decyzja należy w tym przypadku do lekarza.
Kluczowe informacje
- Alergia na jad owadów dotyka sporą liczbę osób. Na szczęście rzadko przybiera groźną dla życia postać.
- Alergia na jad owadów objawia się zaczerwienieniem skóry, pokrzywką, osłabieniem czy obrzękiem. W skrajnych przypadkach dochodzą do tego problemy z oddychaniem, zaburzenia świadomości i nagły spadek ciśnienia krwi.
- Osoby uczulone na jad owadów powinny ich przede wszystkim unikać. Czasem wykonywane jest odczulanie. Poza tym wprowadza się leczenie farmakologiczne.
Najczęściej zadawane pytania
Jak leczyć uczulenie na jad owadów błonkoskrzydłych?
Najlepiej jest unikać owadów, co oczywiście nie zawsze jest możliwe. Czasem przeprowadza się odczulanie, ale nie sprawdza się ono u wszystkich pacjentów. Czasem jedynym rozwiązaniem są leki np. antyhistaminowe czy glikokortykosterydy.
Jak sprawdzić czy jest się uczulonym na jad owadów?
Objawy uczulenia na jad owadów nie są trudne do zauważenia. Trudniej jest dokładnie określić, który owad stoi za uczuleniem. Do tego są już potrzebne specjalistyczne testy.
Ubezpieczenie zdrowotne
Sprawdź oferty ubezpieczeń zdrowotnych i wybierz pakiet dopasowany do Twoich potrzeb. Prywatna opieka medyczna bez kolejek.
Kup ubezpieczenieOpieka medyczna dla Ciebie i rodziny